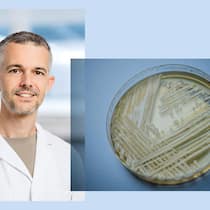
«Die meisten Spitalinfektionen entstehen durch körpereigene Bakterien» Collage aus Keystone-Bild 676806563_highres: ARCHIV - 23.01.2018, Bayern, W¸rzburg: Der Hefepilz Candidozyma auris (fr¸her bekannt als Candida auris) in einer Petrischale, aufgenommen in einem Labor der Universit‰t in W¸rzburg. (zu dpa: ´Kranke…

Tödliche Spitalkeime: Bundesrat ignoriert Gefahr seit Jahren
Ein 18-jähriges Brandopfer von Crans-Montana war mit einem Spitalkeim infiziert. Ein Einzelfall? Nein. Experten warnen seit 2012 vor den resistenten Erregern – ohne Erfolg.

Veröffentlicht am 3. Februar 2026 - 13:53 Uhr

Zürcher Unispital: Ein kürzlich verstorbenes Crans-Montana-Brandopfer war mit einem Spitalkeim infiziert.
Es ist eine Nachricht, die fassungslos macht: Ein 18-jähriger Basketballspieler aus Lausanne, der die verheerende Brandkatastrophe von Crans-Montana überlebt hatte, starb am Samstag im Universitätsspital Zürich (USZ).
Besonders tragisch: Laut «Inside Paradeplatz» erlag der junge Mann, der die beste Prognose aller Patienten gehabt haben soll, nicht direkt seinen Brandverletzungen, sondern einem Spitalkeim.
Ein USZ-Sprecher verweist zur Todesursache auf die Staatsanwaltschaft Wallis, bestätigt aber dem Beobachter: «Wir betreuen zwei Crans-Montana-Patienten mit einem antibiotikaresistenten Acinetobacter baumannii, darunter ist auch der am Samstag gestorbene Patient. Acinetobacter baumannii tritt leider immer wieder im Zusammenhang mit der Behandlung von schwer brandverletzten Patienten auf.»
Trotz wiederholter Warnungen des Bundesamtes für Gesundheit (BAG) und kritischer Berichte von Swissmedic wurden in den letzten Jahren kaum Fortschritte bei der Infektionsrate erzielt.
Der Fall rückt ein heikles Kapitel des Schweizer Gesundheitswesens ins Rampenlicht: Spitalinfektionen führen jährlich zu rund 5900 Toten. Der Beobachter enthüllte diesen Missstand bereits 2023.
Der Grund für die vielen Toten ist mangelnde Hygiene, wie eine Studie des Nationalen Zentrums für Infektionsprävention Swissnoso ergab. Die Anzahl Todesfälle basierte zwar auf Hochrechnungen, sagte damals Studienleiter Walter Zingg von Swissnoso gegenüber dem Beobachter. «Wir denken aber, dass sie sehr nahe an der Realität liegen.»
Bundesrat warnte bereits 2012 vor der Gefahr
Und der Missstand beschäftigt Behörden und Politik seit über zehn Jahren. So reichte die damalige Thurgauer SP-Nationalrätin Edith Graf-Litscher 2012 bereits einen Vorstoss dazu ein. Der Bundesrat lehnte die Motion zwar ab, räumte aber ein, dass bei den Infektionsraten in den Spitälern «ein wesentliches Verbesserungspotenzial» bestehe.
«Ich hoffe sehr, dass die Spitalleitungen den Handlungsbedarf endlich ernst nehmen und die notwendigen Verbesserungen zur Verhinderung von Infektionen im Spital umgehend anpacken», sagte Graf-Litscher 2023 dem Beobachter.
Dennoch wurden – trotz wiederholter Warnungen des Bundesamtes für Gesundheit (BAG) und kritischer Berichte von Swissmedic – in den letzten Jahren kaum Fortschritte bei der Infektionsrate erzielt. Und dies, obwohl Experten wie Walter Zingg von Swissnoso etwa die Hälfte der Infektionen für vermeidbar halten.
Unnötige Antibiotika und neue Krebstherapien
Das Problem sei komplex, sagte Zingg. Durch die demografische Verschiebung der Gesellschaft seien Patientinnen und Patienten heute älter und kränker. Und neue Krebstherapien hätten den Preis, dass sie das Immunsystem schwächen. Dies könne erklären, warum die Infektionsraten «nur» stabil blieben und nicht sinken würden.
Die SPO Patientenorganisation sieht in den teilweise zunehmenden Antibiotika-Resistenzen eine weitere wichtige Ursache für die Spitalinfektionen: «Ein Grund sind unnötige Antibiotikaverschreibungen an Patienten und Patientinnen. Bakterien können dadurch Resistenzen entwickeln, die Medikamente verlieren ihre Wirksamkeit.»
Die Folge sind tragische Schicksale wie jenes des Brandopfers von Crans-Montana. Immerhin berichtet der USZ-Sprecher: «In den letzten vier Wochen konnten wir weitere Infektionen verhindern.» Doch bleibt die Behandlung der Brandopfer eine grosse Herausforderung, da sie unter schwersten Verletzungen leiden, besonders wegen gravierender Lungenschäden durch das Feuer.
- Studie des Nationalen Zentrums für Infektionsprävention Swissnoso
- Vorstoss 2012 von SP-Nationalrätin Edith Graf-Litscher
- Artikel «Inside Paradeplatz»: Brandopfer starb im Uni-Spital an Krankenhaus-Keim